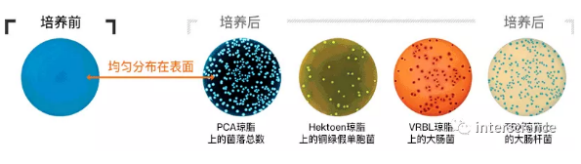
4-7.png

全自动样品接种
easySpiral Pro Milk全程具有可追溯性的全自动接种仪

easySpiral Pro Milk 是一台自动培养皿接种仪。它可接受从100到 1x107 CFU / mL的任何样品无需稀释,直接接种到单独一个培养皿上。easySpiral Pro Milk特别适合乳制品行业,用于原材料分析和牛奶检测。
牛奶检测
基于质量的牛奶支付分析包含营养成分和细菌标准。该结果将决定牛奶的质量和价值。

直接吸取
easySpiral Pro Milk 允许在接种前从原容器(例如:试管,烧杯…)中直接移取样品。不再需要将样品转移到专用容器中吸取,从而避免产生交叉污染的风险。easySpiral Pro Milk 是贵中/珍贵样品的理想选择(例如:活性物质…)。

螺旋方法
使用螺旋方法,可以增加分析能力:无需中间稀释,在单个培养皿上完成标准化从 100 到1 x 107 CFU/mL 的自动接种!


一个接触接种
简单且快速地在90和150毫米培养皿上接种。从3种接种模式选择:指数,均一和循环。
指数模式
指数模式是一种表面浓度递减的表面接种。接种体积可选50 μL, 100 μL, 200 μL或自定义编辑体积获得100至1x107 CFU/mL的可计数培养皿

均一模式
均一模式是一种均匀涂布的表面接种。接种体积可选50 μL, 100 μL, 200 μL或自定义编辑体积。因为在培养皿边缘无菌落,所以菌落计数很容易进行。
高速自动化
快速旋转的手臂可自我调节以适应所有类型的琼脂,避免接种污染的可能性。 可以在25秒内完成一次接种(消毒+取样+接种)。
使用dataLink数据连接确保可追溯
所有样品数据,从接种(体积,稀释,接种模式…)到自动菌落计数(灯光设置)都设置在DataMatrix二维码标签上。



